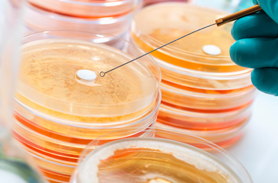
梅花扳手檢測

滲氮鋼檢測
健明迪檢測提供的滲氮鋼檢測,檢測項目:指標檢測,硬度檢測,成分分析,工業問題診斷等,檢測標準參考:GB/T37618-2019滲氮鋼,具有CMA,CNAS認證資質。

檢測流程
1、溝通檢測產品、項目、需求。
2、郵遞寄樣或者上門取樣。
3、確定報價,定制專屬方案。
4、簽訂合同和保密協議
5、開始規劃化實驗
6、實驗結束后,出具原始數據檢測報告。
6、郵寄檢測報告
7、增值服務
為什么企業需要進行第三方檢測
產品研發:成分分析,分析成分比例,改善生產缺陷,提升產品品質性能
政府監管:工商檢測,市場監督,項目投標招標,申請退稅基金等
上市品控:保證自己的產品能順利進入各種電商品臺,商超等
打通市場:增強企業的認知可信度,擴大市場占有率,提高企業競爭力,彰顯產品品質
工業診斷:為您解決工藝、材料中的未知物定性定量分析服務
檢測標準參考
DIN EN 10085-2001滲氮鋼.交貨技術條件
GB/T 37618-2019滲氮鋼
VDI/VDE 3902-1985精密機械材料 調質鋼和滲氮鋼